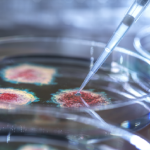

أفاد طبيب الأعصاب بافل فرولوف، أن أعراض ضعف الذاكرة، وخدر الأطراف، ومشكلات الحركة، وتدهور الرؤية قد تشير إلى وجود مشكلات في الجهاز العصبي، تستدعي استشارة الطبيب.
ووفقا له، يشخص طبيب الأعصاب السبب ويعالج الأمراض المتعلقة بالجهاز العصبي والوظائف الإدراكية. لذلك ينبغي استشارة الطبيب في حال وجود أي مشكلات في الذاكرة، أو التركيز، أو التعرف على الوجوه، بالإضافة إلى أي اضطرابات حركية أو حسية.ويقول: “طبيب الأعصاب مسؤول عن الأعصاب والقدرات الإدراكية. إذا بدأ الشخص يعاني من مشكلات في الذاكرة، أو الحساب، أو التعرف على الأشياء، أو إذا ظهرت اضطرابات حركية في الذراعين أو الساقين، أو خدر، أو زيادة في الحساسية، فهذا سبب وجيه لاستشارة الطبيب. كما تندرج مشكلات الرؤية، أو السمع، أو البلع ضمن هذا السياق، لأن الأعصاب القحفية تتحكم بها”.